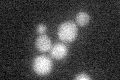
YKL157W

View description
Aminopeptidase yscII; may have a role in obtaining leucine from dipeptide substrates; sequence coordinates have changed since RT-PCR analysis showed that the adjacent ORF YKL158W comprises the 5' exon of APE2/YKL157W
Localization:
Intensity:
Fold change:
Significance:
-
C’ GFP library in SD
below threshold16.75 -
N' NOP1pr-GFP in SD

N/A0 -
N' TEF2pr-mCherry in SD

N/A0 -
N' NATIVEpr-GFP in SD

N/A0 -
N' TEF2pr-VC and Cyto-VN in SD

N/A0 -
C’ GFP library in SD+DTT

cytosol15.360.91No -
C’ GFP library in SD+H2O2

cytosol19.171.14No -
C’ GFP library in Starvation Media

cytosol16.250.96No -
C’ GFP library on the background of Pup2-DaMP

below threshold -
C’ GFP library on the background of CCT mutant

below threshold19.35811.15533No
